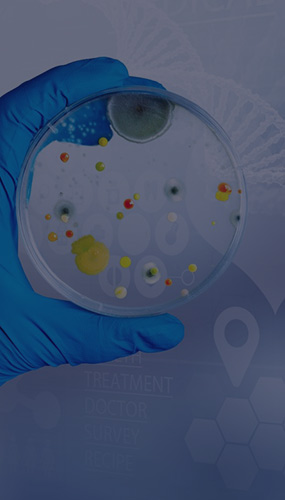

可浸提物/可沥滤物 (E&L)研究
材料/器械等同性研究
毒理学风险评估

医疗器械与药物相容性研究
医疗器械与包装材料相容性研究


细胞毒性
刺激(皮肤/皮内/粘膜等)
致敏试验
热原/细菌内毒素
急性/亚急性/亚慢性/慢性全身毒性
血液相容性


降解产物定性与定量分析
·医疗器械生物学评价第18部分:风险管理过程中医疗器械材料化学表征 GB/T 16886.18-ISO 10993-18
·《医疗器械已知可沥滤物测定方法验证及确认注册技术审查指导原则》
·医疗器械生物学评价第17部分:可沥滤物允许限量的建立GB/T 16886.17-ISO 10993-17
·化学药品与弹性体密封件相容性研究技术指导原则(试行)
·化学药品注射剂与塑料包装材料相容性研究技术指导原则(试行)
·化学药品注射剂与药用玻璃包装容器相容性
·Y BB 00142002-2015药品包装材料与药物相容性试验指导原则
·YYT 1550.1-2017一次性使用输液器具与药物相容性研究指南第1部分:药物吸附研究
·YYT 1550.2-2019一次性使用输液器具与药物相容性研究指南第1部分:已知可沥滤物研究
GB/T 16886-ISO 10993系列标准
·医疗器械生物学评价第9部分:潜在降解产物的定性和定量框架GB/T 16886.9-ISO 10993-9
·医疗器械生物学评价第13部分:聚合物医疗器械的降解产物的定性与定量GB/T 16886.13-ISO 10993-13
·医疗器械生物学评价第14部分:陶瓷降解产物的定性与定量GB/T 16886.14-ISO 10993-14
·医疗器械生物学评价第15部分:金属与合金降解产物的定性与定量GB/T 16886.15-ISO 10993-15

微谱,大型研究型检测机构,始于2008年,总部位于上海,是科技服务改变世界的践行者
微谱聚焦先进制造、生物医药、美丽健康、生态环境、食品农产品五大领域,向社会提供分析测试、检测评价、研发服务、计量校准、认证审核、知识产权六大服务,全方位的技术解决方案助力客户取得更大成功。
微谱现已在全国30多个城市设立分子公司以及50多个专业实验室,拥有3000余名专业人员。
微谱始终秉承“服务,不止于检测!”的理念,尽心尽力让科技进步更快,让产品质量更好,让人类生活更安全、更健康、更绿色!
微谱拥有强大的仪器平台和数据库,10余年行业经验的技术团队





*以上提及的资质、荣誉等相关数据来源:微谱科技集团旗下分子公司及其关联公司;以上提及的各项业务,由拥有相应业务资质的微谱科技集团旗下分子公司及其关联公司承接;其中专利代理业务由上海微略知识产权代理有限公司全权受理。